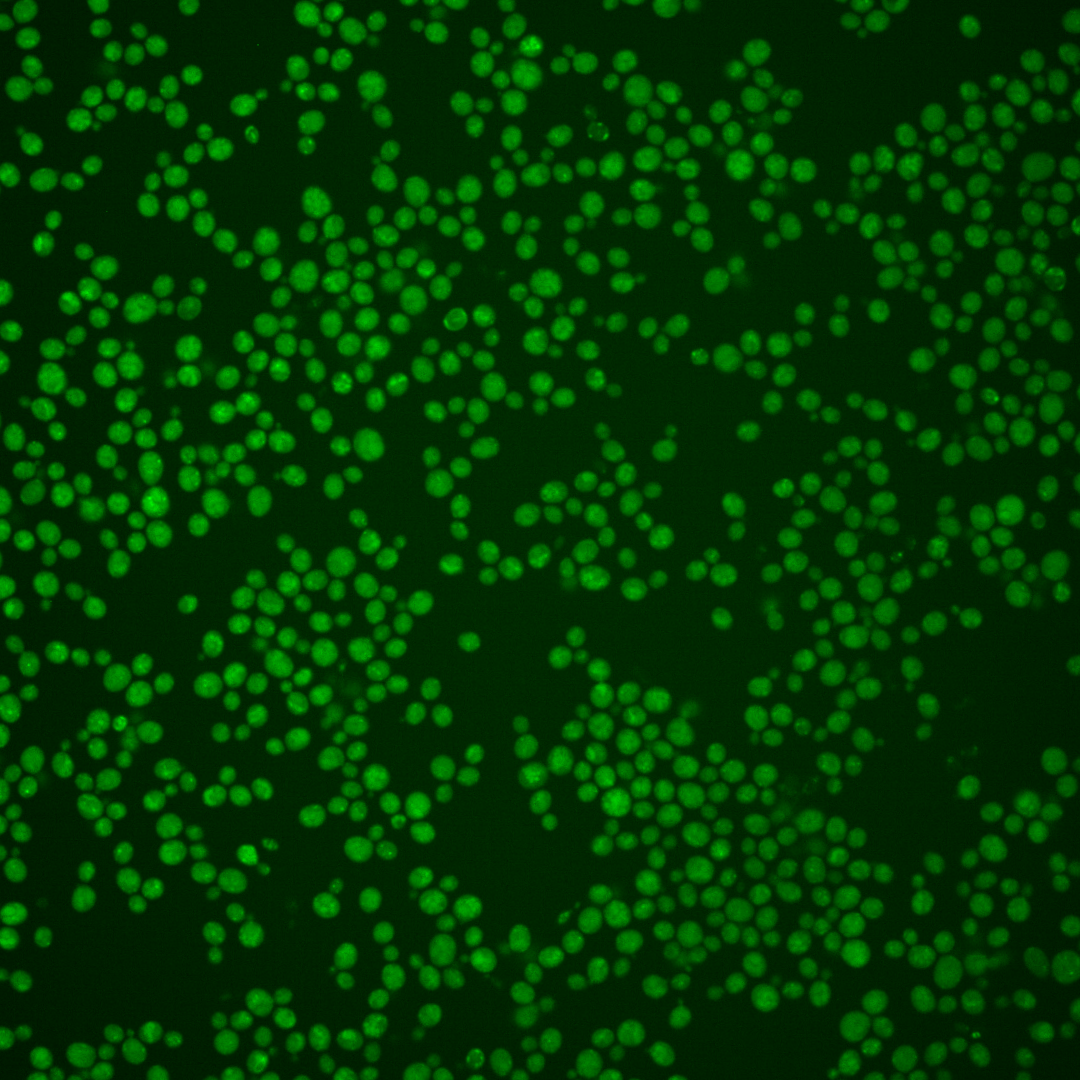

| Standard name | |
|---|---|
| Human Ortholog | |
| Description | ER protein with chaperone and co-chaperone activity; involved in retention of resident ER proteins; has a role in recognizing proteins targeted for ER-associated degradation (ERAD), member of the protein disulfide isomerase family |
Micrographs




















































































Sub-cellular Localization
Yeast GFP Assignment
Protein Abundance
Localization Change
External localization resources
| ensLOC | DeepLoc | |||||||||||||||||||||||
|---|---|---|---|---|---|---|---|---|---|---|---|---|---|---|---|---|---|---|---|---|---|---|---|---|
| Localization | WT1 | WT2 | WT3 | RAP60 | RAP140 | RAP220 | RAP300 | RAP380 | RAP460 | RAP540 | RAP620 | RAP700 | HU80 | HU120 | HU160 | rpd3Δ_1 | rpd3Δ_2 | rpd3Δ_3 | WT1 | WT2 | WT3 | AF100 | AF140 | AF180 |
| Cortical Patches | 0 | 0 | 0 | 0 | 0 | 0 | 0 | 0 | 0 | 0 | 0 | 1 | 0 | 1 | 0 | 0 | 0 | 0 | 0 | 0 | 0 | 1 | 0 | 1 |
| Bud | 0 | 0 | 1 | 0 | 0 | 0 | 0 | 0 | 0 | 1 | 1 | 1 | 2 | 2 | 1 | 0 | 0 | 1 | 0 | 1 | 0 | 1 | 0 | 2 |
| Bud Neck | 0 | 0 | 0 | 0 | 0 | 0 | 0 | 0 | 0 | 0 | 0 | 0 | 2 | 2 | 1 | 0 | 0 | 0 | 0 | 0 | 0 | 0 | 0 | 0 |
| Bud Site | 0 | 0 | 0 | 0 | 0 | 0 | 0 | 0 | 0 | 0 | 0 | 0 | 0 | 0 | 0 | 0 | 0 | 0 | – | – | – | – | – | – |
| Cell Periphery | 0 | 0 | 0 | 0 | 0 | 0 | 0 | 0 | 0 | 0 | 0 | 0 | 0 | 0 | 1 | 0 | 0 | 0 | 0 | 0 | 0 | 0 | 0 | 0 |
| Cytoplasm | 30 | 36 | 29 | 54 | 79 | 108 | 211 | 266 | 201 | 183 | 233 | 264 | 113 | 113 | 80 | 74 | 51 | 25 | 0 | 2 | 0 | 1 | 7 | 6 |
| Endoplasmic Reticulum | 0 | 0 | 0 | 0 | 1 | 0 | 4 | 1 | 0 | 1 | 0 | 2 | 3 | 0 | 0 | 10 | 11 | 9 | 0 | 0 | 0 | 0 | 3 | 2 |
| Endosome | 5 | 0 | 7 | 10 | 16 | 7 | 7 | 2 | 1 | 0 | 0 | 1 | 7 | 6 | 1 | 4 | 6 | 7 | 16 | 12 | 7 | 12 | 19 | 27 |
| Golgi | 0 | 0 | 0 | 0 | 0 | 0 | 0 | 0 | 0 | 0 | 0 | 0 | 0 | 0 | 0 | 1 | 0 | 3 | 1 | 1 | 1 | 2 | 0 | 3 |
| Mitochondria | 27 | 67 | 47 | 10 | 16 | 35 | 33 | 44 | 52 | 52 | 55 | 55 | 0 | 0 | 0 | 17 | 15 | 8 | 12 | 6 | 8 | 5 | 12 | 15 |
| Nucleus | 70 | 32 | 15 | 13 | 9 | 17 | 26 | 32 | 16 | 16 | 12 | 22 | 5 | 5 | 3 | 87 | 62 | 43 | 7 | 2 | 0 | 1 | 4 | 2 |
| Nuclear Periphery | 2 | 2 | 0 | 0 | 1 | 0 | 4 | 5 | 8 | 3 | 2 | 6 | 0 | 0 | 0 | 2 | 0 | 0 | 6 | 0 | 0 | 1 | 4 | 2 |
| Nucleolus | 0 | 0 | 0 | 0 | 0 | 1 | 0 | 0 | 0 | 1 | 1 | 1 | 0 | 0 | 0 | 0 | 0 | 1 | 0 | 0 | 0 | 1 | 1 | 0 |
| Peroxisomes | 0 | 0 | 0 | 0 | 2 | 0 | 0 | 0 | 0 | 0 | 0 | 0 | 0 | 0 | 0 | 0 | 0 | 0 | 0 | 0 | 0 | 0 | 0 | 0 |
| SpindlePole | 1 | 0 | 0 | 0 | 0 | 2 | 3 | 0 | 0 | 0 | 0 | 0 | 1 | 1 | 0 | 0 | 0 | 0 | 0 | 1 | 0 | 1 | 2 | 2 |
| Vac/Vac Membrane | 260 | 231 | 164 | 146 | 221 | 213 | 309 | 317 | 212 | 172 | 164 | 203 | 85 | 72 | 19 | 93 | 81 | 89 | 320 | 275 | 206 | 208 | 328 | 293 |
| Unique Cell Count | 333 | 290 | 217 | 180 | 275 | 292 | 434 | 514 | 371 | 321 | 362 | 428 | 191 | 183 | 98 | 209 | 173 | 138 | 369 | 305 | 231 | 239 | 391 | 367 |
| Labelled Cell Count | 395 | 368 | 263 | 233 | 345 | 383 | 597 | 667 | 490 | 429 | 468 | 556 | 218 | 202 | 106 | 288 | 226 | 186 | 369 | 305 | 231 | 239 | 391 | 367 |
Yeast GFP Assignment
Protein Abundance
| Screen | WT1 | WT2 | WT3 | RAP60 | RAP140 | RAP220 | RAP300 | RAP380 | RAP460 | RAP540 | RAP620 | RAP700 | HU80 | HU120 | HU160 | rpd3Δ_1 | rpd3Δ_2 | rpd3Δ_3 | AF100 | AF140 | AF180 |
|---|---|---|---|---|---|---|---|---|---|---|---|---|---|---|---|---|---|---|---|---|---|
| Mean Cell GFP Intensity (1e-4) | 6.3 | 5.6 | 5.7 | 6.4 | 6.8 | 5.7 | 5.6 | 5.6 | 5.1 | 4.8 | 4.9 | 5.1 | 6.2 | 6.2 | 5.9 | 5.1 | 5.8 | 6.8 | 7.0 | 6.7 | 7.1 |
| Std Deviation (1e-4) | 1.3 | 1.2 | 1.6 | 1.8 | 1.7 | 1.6 | 1.5 | 1.6 | 1.3 | 1.1 | 1.4 | 1.2 | 1.4 | 1.4 | 1.7 | 1.1 | 1.4 | 1.6 | 1.7 | 1.5 | 1.9 |
| Intensity Change (Log2) | – | – | – | 0.18 | 0.26 | 0.01 | -0.01 | -0.02 | -0.15 | -0.24 | -0.2 | -0.16 | 0.13 | 0.13 | 0.06 | -0.15 | 0.03 | 0.27 | 0.3 | 0.25 | 0.33 |
Localization Change
| Localization | RAP60 | RAP140 | RAP220 | RAP300 | RAP380 | RAP460 | RAP540 | RAP620 | RAP700 | HU80 | HU120 | HU160 | rpd3Δ_1 | rpd3Δ_2 | rpd3Δ_3 |
|---|---|---|---|---|---|---|---|---|---|---|---|---|---|---|---|
| Cortical Patches | 0 | 0 | 0 | 0 | 0 | 0 | 0 | 0 | 0 | 0 | 0 | 0 | 0 | 0 | 0 |
| Bud | 0 | 0 | 0 | 0 | 0 | 0 | 0 | 0 | 0 | 0 | 0 | 0 | 0 | 0 | 0 |
| Bud Neck | 0 | 0 | 0 | 0 | 0 | 0 | 0 | 0 | 0 | 0 | 0 | 0 | 0 | 0 | 0 |
| Bud Site | 0 | 0 | 0 | 0 | 0 | 0 | 0 | 0 | 0 | 0 | 0 | 0 | 0 | 0 | 0 |
| Cell Periphery | 0 | 0 | 0 | 0 | 0 | 0 | 0 | 0 | 0 | 0 | 0 | 0 | 0 | 0 | 0 |
| Cytoplasm | 4.1 | 4.1 | 5.9 | 8.8 | 9.7 | 9.8 | 10.2 | 11.9 | 11.6 | 9.7 | 10.1 | 11.8 | 5.3 | 3.9 | 1.2 |
| Endoplasmic Reticulum | 0 | 0 | 0 | 0 | 0 | 0 | 0 | 0 | 0 | 0 | 0 | 0 | 0 | 0 | 0 |
| Endosome | 1.1 | 1.4 | -0.6 | 0 | 0 | 0 | 0 | 0 | 0 | 0.2 | 0 | 0 | -0.9 | 0.1 | 0.9 |
| Golgi | 0 | 0 | 0 | 0 | 0 | 0 | 0 | 0 | 0 | 0 | 0 | 0 | 0 | 0 | 0 |
| Mitochondria | -4.6 | -5.2 | -2.9 | -5.1 | -4.9 | -2.4 | 0 | -2.0 | -2.9 | -6.8 | -6.7 | -5.0 | -3.9 | -3.5 | -4.0 |
| Nucleus | 0.1 | -1.9 | -0.5 | -0.5 | -0.3 | -1.4 | -0.9 | -2.0 | -0.9 | -2.0 | -1.9 | -1.4 | 8.4 | 7.1 | 6.0 |
| Nuclear Periphery | 0 | 0 | 0 | 0 | 0 | 0 | 0 | 0 | 0 | 0 | 0 | 0 | 0 | 0 | 0 |
| Nucleolus | 0 | 0 | 0 | 0 | 0 | 0 | 0 | 0 | 0 | 0 | 0 | 0 | 0 | 0 | 0 |
| Peroxisomes | 0 | 0 | 0 | 0 | 0 | 0 | 0 | 0 | 0 | 0 | 0 | 0 | 0 | 0 | 0 |
| SpindlePole | 0 | 0 | 0 | 0 | 0 | 0 | 0 | 0 | 0 | 0 | 0 | 0 | 0 | 0 | 0 |
| Vacuole | 1.3 | 1.3 | -0.7 | -1.2 | -3.6 | -4.5 | -5.2 | -7.1 | -6.8 | -6.4 | -7.3 | -9.4 | -6.6 | -5.8 | -2.2 |
External localization resources
Images






























Protein Concentration and Protein Localization Data
| R1 | R2 | R3 | ||||||||||||||||
|---|---|---|---|---|---|---|---|---|---|---|---|---|---|---|---|---|---|---|
| G1 Pre-START | G1 Post-START | S/G2 | Metaphase | Anaphase | Telophase | G1 Pre-START | G1 Post-START | S/G2 | Metaphase | Anaphase | Telophase | G1 Pre-START | G1 Post-START | S/G2 | Metaphase | Anaphase | Telophase | |
| Concentration | 1.6476 | 2.7373 | 2.0418 | 1.9911 | 1.6676 | 2.2762 | 2.4594 | 3.6835 | 3.1717 | 2.9013 | 3.1141 | 3.4375 | 2.6661 | 3.7614 | 3.1885 | 3.5936 | 2.9123 | 3.4412 |
| Actin | 0.0169 | 0.0053 | 0.0098 | 0 | 0.0036 | 0.0007 | 0.0188 | 0 | 0.0021 | 0.0086 | 0.0561 | 0.0004 | 0.0095 | 0 | 0.0056 | 0 | 0.0102 | 0.0002 |
| Bud | 0.0006 | 0.0005 | 0.0005 | 0.0003 | 0.0006 | 0.0018 | 0.0031 | 0.0003 | 0.0005 | 0.0008 | 0.0009 | 0.0003 | 0.0004 | 0.0003 | 0.0005 | 0.0002 | 0.0004 | 0.0007 |
| Bud Neck | 0.0016 | 0.0011 | 0.002 | 0.0007 | 0.0012 | 0.0008 | 0.0011 | 0.0008 | 0.0009 | 0.0106 | 0.0012 | 0.001 | 0.0016 | 0.0014 | 0.001 | 0.0004 | 0.0009 | 0.0012 |
| Bud Periphery | 0.0013 | 0.0008 | 0.0009 | 0.0006 | 0.0009 | 0.0009 | 0.0036 | 0.0005 | 0.0012 | 0.0015 | 0.0021 | 0.0006 | 0.0009 | 0.0006 | 0.001 | 0.0003 | 0.0008 | 0.0015 |
| Bud Site | 0.0021 | 0.0019 | 0.0021 | 0.0009 | 0.0016 | 0.0005 | 0.0053 | 0.0015 | 0.0014 | 0.0073 | 0.0019 | 0.0006 | 0.0016 | 0.001 | 0.001 | 0.0005 | 0.0016 | 0.0014 |
| Cell Periphery | 0.0011 | 0.0009 | 0.001 | 0.0006 | 0.0008 | 0.001 | 0.0009 | 0.0012 | 0.0012 | 0.0026 | 0.0006 | 0.0009 | 0.0017 | 0.0132 | 0.0011 | 0.0006 | 0.0006 | 0.0011 |
| Cytoplasm | 0.0161 | 0.0253 | 0.0106 | 0.0048 | 0.01 | 0.0118 | 0.0091 | 0.0194 | 0.0161 | 0.0038 | 0.0031 | 0.0062 | 0.0126 | 0.0148 | 0.0164 | 0.0037 | 0.0165 | 0.0141 |
| Cytoplasmic Foci | 0.0186 | 0.0086 | 0.0236 | 0.0086 | 0.0156 | 0.0076 | 0.0171 | 0.0168 | 0.0148 | 0.0204 | 0.0391 | 0.01 | 0.0142 | 0.011 | 0.0143 | 0.0062 | 0.014 | 0.0078 |
| Eisosomes | 0.0001 | 0 | 0.0001 | 0 | 0.0001 | 0 | 0.0002 | 0 | 0.0002 | 0.0002 | 0.0004 | 0 | 0.0008 | 0 | 0.0001 | 0 | 0.0001 | 0 |
| Endoplasmic Reticulum | 0.0057 | 0.0032 | 0.0037 | 0.0016 | 0.0052 | 0.0031 | 0.0043 | 0.006 | 0.0069 | 0.002 | 0.0048 | 0.0044 | 0.0053 | 0.0078 | 0.0062 | 0.0011 | 0.0035 | 0.0057 |
| Endosome | 0.3194 | 0.2078 | 0.3173 | 0.3336 | 0.334 | 0.2216 | 0.3369 | 0.2589 | 0.3461 | 0.3719 | 0.381 | 0.3074 | 0.3343 | 0.2175 | 0.3149 | 0.3079 | 0.2662 | 0.2709 |
| Golgi | 0.014 | 0.0049 | 0.0157 | 0.009 | 0.0183 | 0.0103 | 0.0172 | 0.0058 | 0.0195 | 0.0254 | 0.0203 | 0.0118 | 0.0109 | 0.0055 | 0.01 | 0.0048 | 0.0083 | 0.007 |
| Lipid Particles | 0.0104 | 0.0062 | 0.0156 | 0.0067 | 0.0103 | 0.0205 | 0.0104 | 0.0074 | 0.0056 | 0.0192 | 0.0183 | 0.0059 | 0.0197 | 0.0036 | 0.0049 | 0.0038 | 0.0123 | 0.0118 |
| Mitochondria | 0.0218 | 0.008 | 0.0175 | 0.0325 | 0.0081 | 0.0184 | 0.038 | 0.004 | 0.0291 | 0.0136 | 0.021 | 0.0102 | 0.0298 | 0.0041 | 0.0284 | 0.002 | 0.0071 | 0.0052 |
| None | 0.014 | 0.0043 | 0.013 | 0.0002 | 0.0019 | 0.0035 | 0.0042 | 0.0045 | 0.023 | 0.0011 | 0.0004 | 0.0028 | 0.0095 | 0.001 | 0.0175 | 0.0001 | 0.0027 | 0.0004 |
| Nuclear Periphery | 0.0252 | 0.0076 | 0.0071 | 0.0031 | 0.0168 | 0.0061 | 0.0115 | 0.0238 | 0.0095 | 0.0025 | 0.0038 | 0.0068 | 0.0052 | 0.0082 | 0.0073 | 0.0025 | 0.0128 | 0.0063 |
| Nucleolus | 0.0051 | 0.0014 | 0.0029 | 0.0018 | 0.0015 | 0.0013 | 0.0012 | 0.0022 | 0.002 | 0.0054 | 0.0008 | 0.001 | 0.0062 | 0.0009 | 0.0012 | 0.0007 | 0.0015 | 0.0016 |
| Nucleus | 0.0084 | 0.0037 | 0.0035 | 0.0018 | 0.0063 | 0.0029 | 0.0036 | 0.0038 | 0.0064 | 0.0022 | 0.002 | 0.0018 | 0.0059 | 0.0056 | 0.0024 | 0.0016 | 0.0049 | 0.0075 |
| Peroxisomes | 0.0065 | 0.0007 | 0.0038 | 0.0009 | 0.0026 | 0.0026 | 0.0045 | 0.0005 | 0.001 | 0.0048 | 0.0729 | 0.0009 | 0.0023 | 0.0007 | 0.0011 | 0.0003 | 0.0112 | 0.0029 |
| Punctate Nuclear | 0.0011 | 0.0003 | 0.0009 | 0.0001 | 0.0009 | 0.0004 | 0.001 | 0.0002 | 0.0003 | 0.0002 | 0.0004 | 0.0001 | 0.0013 | 0.0002 | 0.0002 | 0 | 0.0013 | 0.0001 |
| Vacuole | 0.3878 | 0.5646 | 0.4311 | 0.4862 | 0.4708 | 0.5454 | 0.3953 | 0.4898 | 0.3881 | 0.4013 | 0.2996 | 0.4569 | 0.4152 | 0.5802 | 0.4228 | 0.5461 | 0.5231 | 0.5376 |
| Vacuole Periphery | 0.1218 | 0.1429 | 0.1175 | 0.106 | 0.089 | 0.1388 | 0.1126 | 0.1525 | 0.1239 | 0.0947 | 0.0694 | 0.1701 | 0.1108 | 0.1222 | 0.1424 | 0.1171 | 0.1 | 0.115 |
Sequencing Data
| R1 | R2 | |||||||||
|---|---|---|---|---|---|---|---|---|---|---|
| G1 Post-START | S/G2 | Metaphase | Anaphase | Telophase | G1 Post-START | S/G2 | Metaphase | Anaphase | Telophase | |
| Gene Expression | 26.1967 | 24.8233 | 20.1577 | 30.1724 | 22.417 | 30.895 | 26.1644 | 25.41 | 28.8634 | 30.7797 |
| Translational Efficiency | 1.2312 | 0.9043 | 1.3705 | 0.9627 | 1.021 | 1.0382 | 1.1344 | 1.1439 | 0.8937 | 0.9075 |
Hit Data
| Dataset | Hit |
|---|---|
| Protein Concentration | ✘ |
| Protein Localization | ✘ |
| Gene Expression | ✘ |
| Translational Efficiency | ✘ |
Endocytosis
| Temp | Actin Patch (Sac6-tdTomato) | Cortical Patch (Sla1-GFP) | Late Endosome (Snf7-GFP) | Vacuole (Vph1-GFP) |
|---|---|---|---|---|
| 37℃ | ||||
| RT |
Cell Cycle Omics
CYCLoPs (Eps1-GFP)
| Gene / Allele | Actin Patch (Sac6-tdTomato) | Cortical Patch (Sla1-GFP) | Late Endosome (Snf7-GFP) | Vacuole (Sac6-tdTomato) |
|---|
| Gene | Images |
|---|
| Gene | Images |
|---|
Images are not yet available
Images are not yet available